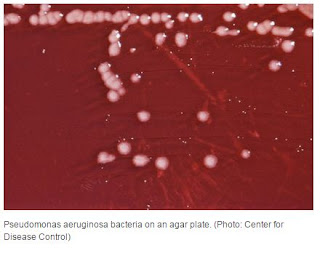

TELUR TETAS
Sumber : http://www.plusvet.eu/how-egg-quality-impacts-the-health-of-day-one-chicks/
Sumber : http://www.plusvet.eu/how-egg-quality-impacts-the-health-of-day-one-chicks/
Karakteristik fisik telur fertil
memainkan peran penting dalam perkembangan embrio, daya tetas dan status
anak-anak ayam.
Penurunan kualitas dimulai segera
setelah telur diletakkan, terutama karena hilangnya air dan CO2. Kehilangan
karbon dioksida menyebabkan peningkatan pH telur, yang menghasilkan perubahan
dalam struktur tiga dimensi dari protein.
Kualitas albumen adalah salah
satu indikator utama yang berhubungan dengan kesegaran. Ketinggian albumen dan
berat telur utuh yang digunakan untuk menghitung nilai Haugh unit. Nilai Haugh
Unit 70-80 ideal untuk telur fertil dan akan jatuh cepat setelah 3-5 hari jika
telur tidak disimpan dengan benar (Ahmadi, 2011).
Tebal cangkang sekitar 0,3 mm dan
terdiri dari lebih dari 95% kalsium karbonat yang distabilkan oleh matriks
protein. Kutikula di atas dan membran bawah shell berfungsi sebagai hambatan.
Hal ini ditutupi hingga 20.000 pori-pori yang memungkinkan pertukaran gas dan
air antara embrio dan lingkungan (La Scala et al, 2000).
Formasi Telur
Egg Shell Pores
1. Pore diameter is in the range 9,0 - 65 µm.
2. a Significant numbers of bacteria only measure 0,3 to 8 µm.
Sumber : Veterinary Word Vol.2, No.2, February 2009
Sumber : http://www.pasreform.com/academy/frequently-asked-questions/hatching-eggs/135-dealing-with-exploders.html
Sumber :http://www.nipoultry.com/yolksacinfection.htm
PSEUDOMONAS
http://science.time.com/2011/07/29/exploding-bacteria-self-fertilizing-bugs-and-other-cool-critters/
The smallest — but easily the most dramatic — of the new critters are the suicide-bomber bacteria discovered by researchers at the University of Oxford and ETH Zürich (think Switzerland’s MIT) and reported in a paper in The American Naturalist. Known by the misleadingly unremarkable name Pseudomonas aeruginosa, the little bugs have a nasty habit of blowing themselves up and releasing a spray of toxins when too many of their fellowPseudomonas aeruginosa are in the vicinity. The detonation kills some of the bystanders and reduces competition for food among the survivors.

Tidak ada komentar:
Posting Komentar